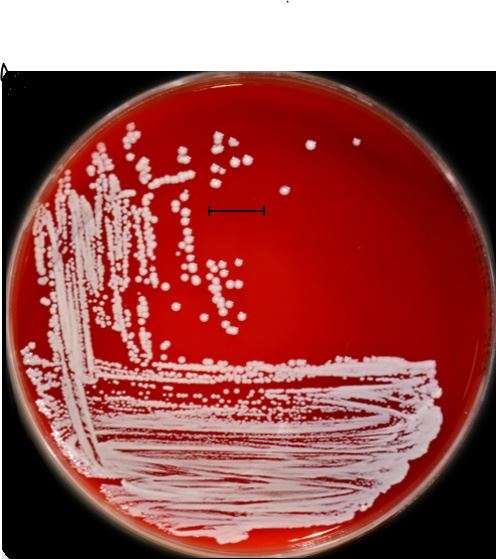

Staphylococcus saprophyticus
Staphylococcus saprophyticus یک باکتری گرممثبت، کروی شکل و بیهوازی اختیاری است که به خانواده Staphylococcaceae تعلق دارد. این باکتری به عنوان یکی از عوامل شایع عفونتهای ادراری (UTIs) در زنان جوان و فعال از نظر جنسی شناخته میشود. برخلاف سایر گونههای استافیلوکوک که معمولاً با عفونتهای بیمارستانی مرتبط هستند، Staphylococcus saprophyticus بیشتر در عفونتهای ادراری اکتسابی از جامعه دیده میشود.
ویژگیهای کلیدی Staphylococcus saprophyticus:
1. گرممثبت: دیواره سلولی ضخیم با لایه پپتیدوگلیکان.
2. کاتالاز مثبت: توانایی تولید آنزیم کاتالاز که هیدروژن پراکسید را به آب و اکسیژن تجزیه میکند.
3. کوآگولاز منفی: برخلاف Staphylococcus aureus، این باکتری کوآگولاز تولید نمیکند.
4. مقاومت به نووبیوسین: این ویژگی به تشخیص Staphylococcus saprophyticus از سایر گونههای استافیلوکوک کمک میکند.
5. چسبندگی به سلولهای اپیتلیال مجاری ادراری: این باکتری میتواند به سلولهای اپیتلیال مجاری ادراری بچسبد و باعث عفونت شود.
بیماریزایی و عفونتها:
Staphylococcus saprophyticus یکی از علل شایع عفونتهای ادراری (UTIs) در زنان جوان (سنین ۱۷ تا ۲۷ سال) است. این باکتری پس از Escherichia coli، دومین عامل شایع عفونتهای ادراری در این گروه سنی محسوب میشود. عفونتهای ناشی از این باکتری معمولاً شامل:
- عفونتهای ادراری تحتانی: مانند سیستیت (التهاب مثانه).
- عفونتهای ادراری فوقانی: مانند پیلونفریت (التهاب کلیه).
عوامل خطر:
- فعالیت جنسی**: احتمال انتقال باکتری به مجاری ادراری را افزایش میدهد.
- استفاده از وسایل پیشگیری از بارداری: مانند دیافراگم یا اسپرمکشها.
- سابقه عفونتهای ادراری قبلی.
تشخیص:
تشخیص Staphylococcus saprophyticus معمولاً از طریق کشت نمونه ادرار و انجام آزمایشهای بیوشیمیایی انجام میشود. ویژگیهای تشخیصی شامل:
- مقاومت به نووبیوسین: این باکتری به نووبیوسین مقاوم است.
- کوآگولاز منفی: برخلاف Staphylococcus aureus، کوآگولاز تولید نمیکند.
درمان:
Staphylococcus saprophyticus معمولاً به آنتیبیوتیکهای رایج مانند نیتروفورانتوئین، تریمتوپریم-سولفامتوکسازول (TMP-SMX) و فلوروکینولونها (مانند سیپروفلوکساسین) حساس است. با این حال، برخی سویهها ممکن است به آنتیبیوتیکهای خاصی مقاوم باشند، بنابراین انجام تست حساسیت آنتیبیوتیکی (آنتیبیوگرام) توصیه میشود.
پیشگیری:
- رعایت بهداشت شخصی: شستن دستها و بهداشت ناحیه تناسلی.
- ادرار کردن پس از رابطه جنسی: برای کاهش خطر انتقال باکتری به مجاری ادراری.
- پرهیز از استفاده طولانیمدت از وسایل پیشگیری از بارداری که خطر عفونت را افزایش میدهند.
جمعبندی:
Staphylococcus saprophyticus یک باکتری گرممثبت و کوآگولاز منفی است که به عنوان یکی از علل شایع عفونتهای ادراری در زنان جوان شناخته میشود. این باکتری به دلیل توانایی چسبیدن به سلولهای اپیتلیال مجاری ادراری و ایجاد عفونت، اهمیت بالینی دارد. تشخیص و درمان به موقع این عفونتها برای پیشگیری از عوارض جدی مانند پیلونفریت ضروری است. رعایت بهداشت شخصی و اقدامات پیشگیرانه میتواند به کاهش خطر عفونت کمک کند.